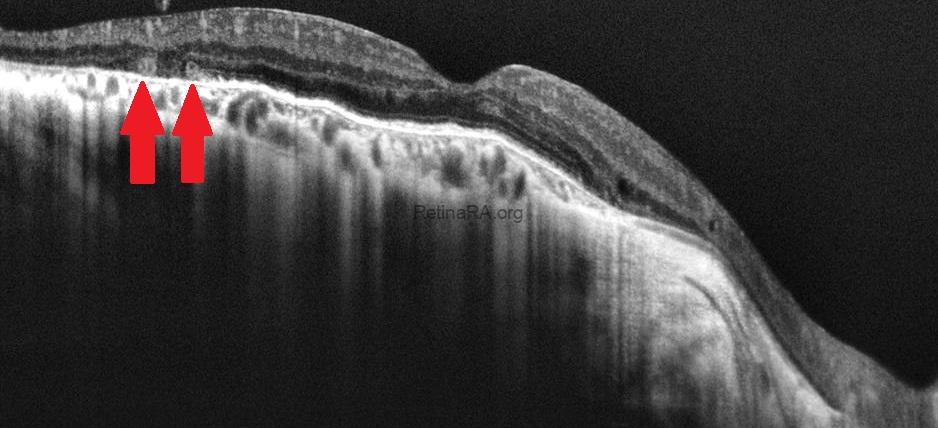
Choroideremia-oct.-1

A 41-year-old male patient diagnosed with choroideremia. Choroideremia is an X-linked hereditary dystrophy characterized by widespread and progressive degeneration of the choriocapillaris, RPE, and photoreceptors. Choroideremia is caused by a mutation in the CHM gene. Since it is X-linked, males with this mutation are severely affected. Due to variable X inactivation, females may be asymptomatic carriers or rarely affected by the dystrophy.
In color fundus photographs, atrophy severe enough to reveal sclera and a central island of healthy retina can be seen. However, autofluorescence images show the boundaries of this healthy retinal island (white arrows) much more clearly. The well-defined polygonal geometric shape of this island is typical of choroideremia.





Outer retinal tubules (red arrows), small cysts, and areas of atrophy are present on OCT of both eyes, as well as a thick ERM on OCT of the left eye.

Credit: M. Giray Ersoz, MD, FEBO, Retina Specialist
Memorial Bahçelievler Hospital, Department of Ophthalmology, Istanbul, Turkey
Arel University School of Medicine, Department of Ophthalmology, Istanbul, Turkey
Instagram accounts: @retina.review and @retina.dr.girayersoz
Website: www.girayersoz.com.tr

